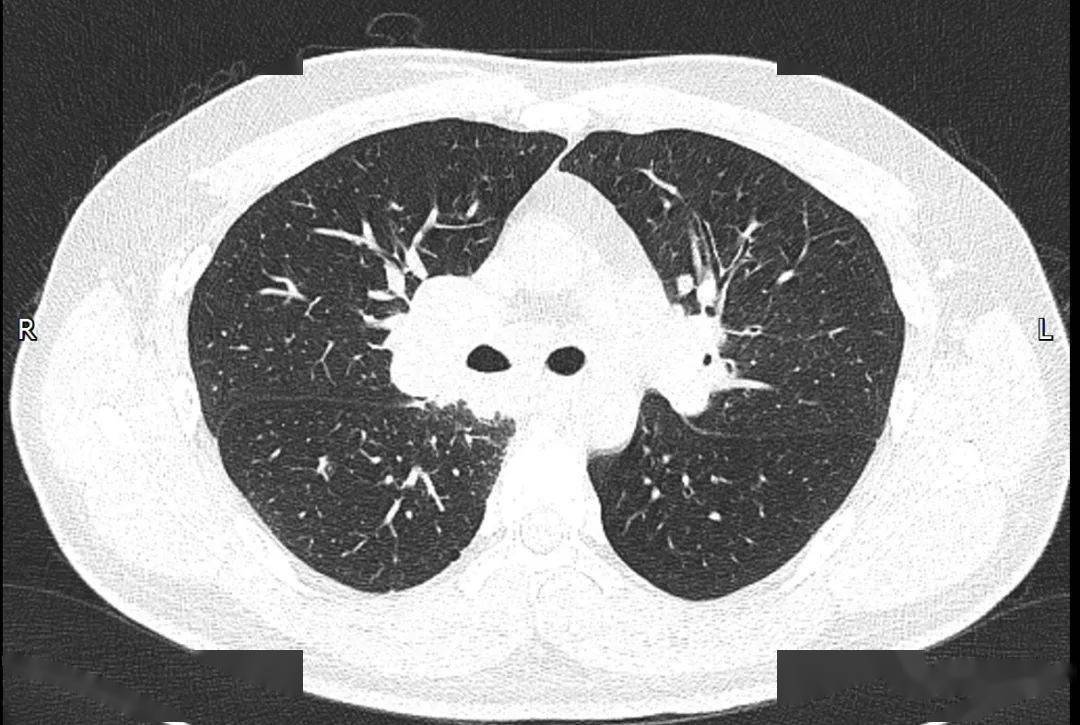
肺结节病
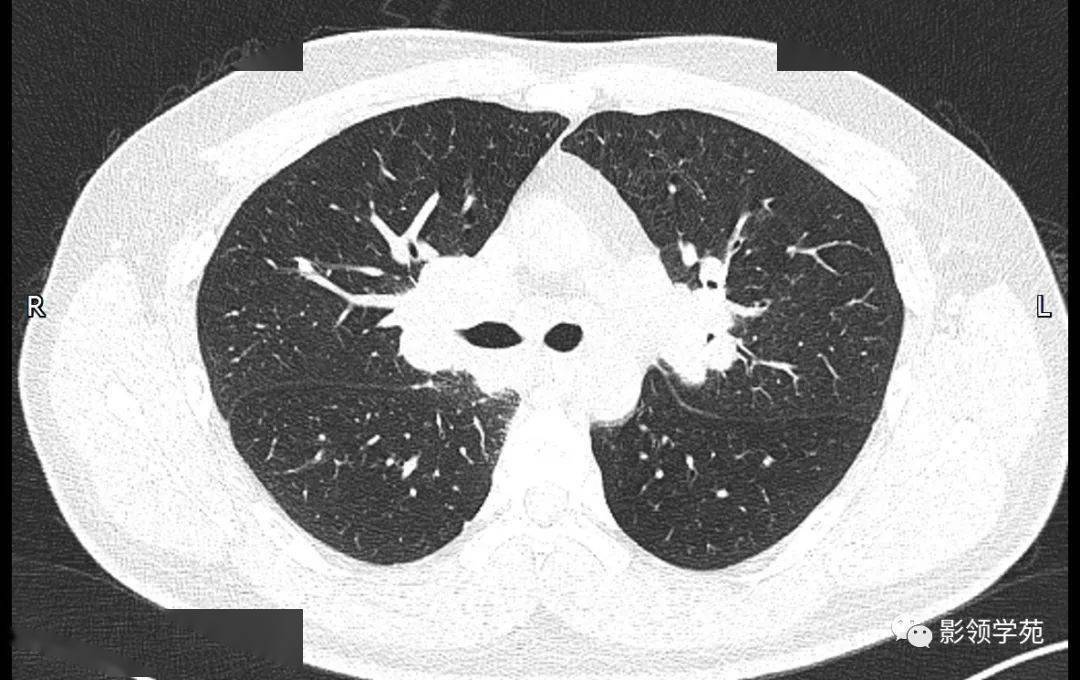
肺结节病

肺结节病

会移动的肺结节.左肺上叶前段胸膜下肺混合型结节,仰卧位扫描( - 抖音
图片尺寸1440x1512
肺结节病
图片尺寸650x436
典型病例,肺结节病
图片尺寸2000x2667
专病门诊∣肺结节与呼吸介入门诊
图片尺寸1057x603
每日晨读经典重现肺结节病
图片尺寸785x878
女性,肺结节大于1厘米,该不该手术切除?
图片尺寸1537x1600
一个患者左肺,右肺两次术后,随访中左下肺磨玻璃结节慢慢露出峥 - 抖
图片尺寸612x468
典型病例,肺结节病
图片尺寸2000x2667
肺结节病的临床症状有什么?_北京崇文中方中医医院
图片尺寸1718x1172
病例肺结节病1例ct影像表现
图片尺寸1080x608
肺结节是什么病严重吗能治好吗?_治疗_检查_评估
图片尺寸1945x1280
专病门诊∣肺结节与呼吸介入门诊
图片尺寸585x493
肺结节_良性肺结节的六个特征-第2张图片-体检知音
图片尺寸1920x1080
肺结节病
图片尺寸560x404
肺结节病
图片尺寸1080x725
结节病能治好吗(肺结节病能治好吗)
图片尺寸1550x1600
病例分析肺结节病
图片尺寸640x480
肺结节病
图片尺寸1080x680
多发肺结节之肺隐球菌病丨小打卡读片精选36
图片尺寸967x2142刘懿博士说肺癌(二五九〇)切之前知道俩肺结节是良性,但不是一种病
图片尺寸1354x1006
猜你喜欢:肺部纯磨玻璃结节肺癌CT图片肺结节病CT肺结节x光肺肿瘤肺结节几毫米是安全的肺结节是怎么形成的肺结节图片正常肺部胸片正常肺对比肺癌ct图片正常肺ct肺小结节正常肺部ct高清图良性肺结节图片肺结节胸片正常的肺部图片肺癌胸片肺结节手术图片结节性皮肤病初期图片肺结节影像图肺结节病ct图片肺部恶性肿瘤ct图片肺癌扩散图片磨玻璃肺部结节肺部结节是怎么回事肺结节吃什么药能散结肺结节症状陈旧性肺结核肺结节ct怎么看图解结节病皮肤表现图片祖峰写真低胸T恤女丧尸围城生化危机森林人保险丝盒翻译图二胡曲春郊试马简谱南瓜病害图片及特效药地图标识牌别克保姆车图片月刊少女野崎君 海报白狐妖 九尾50年代法国时尚快手李牌牌多大